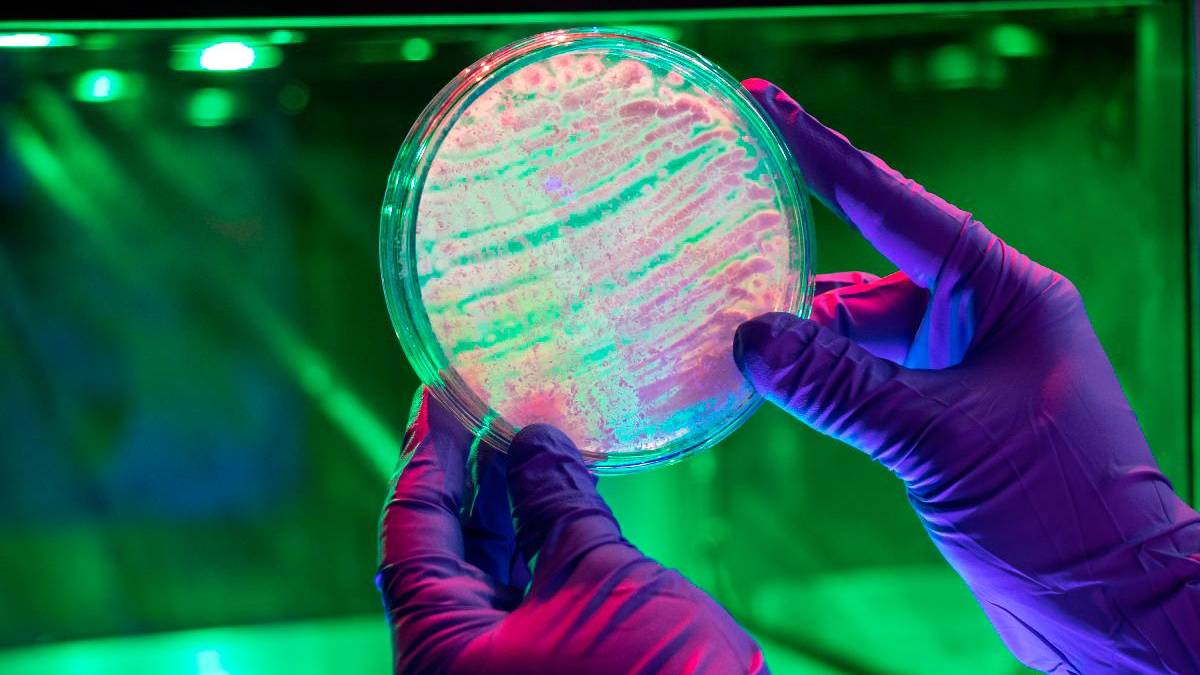

Agrosavia, la institución pública responsable de la investigación agropecuaria en Colombia reconoció la grave situación fiscal por la que atraviesa el país y las acciones que se han tomado desde el Ministerio de Hacienda para garantizar la sostenibilidad económica y el cumplimiento de la regla fiscal.
Para la presente vigencia, el presupuesto destinado a esta corporación tuvo una reducción drástica del 27,5% pasando de $299.325 millones en el 2024 a $216.754 millones en el 2025. “En esa reducción se incluyen $10.000 millones que se encuentran aplazados y que solicitamos se siga considerando como una medida temporal y no un recorte definitivo; de esta manera lograremos disminuir el impacto sobre la institución”, se lee en un comunicado.
De acuerdo con las cuentas de Agrosavia, el presupuesto de 2025 es el más bajo desde que entró en vigencia la Ley 1731 de 2014, a través de la cual se creó la transferencia de recursos para el cumplimiento de la misión de la entidad oficial. “Dada la necesidad de continuar aportando a los objetivos del Plan Nacional de Desarrollo, Agrosavia ha estado en trabajo permanente con el Ministerio de Agricultura y Desarrollo Rural y acordó, como siempre se ha hecho, el Marco de Metas y Resultados que orientará las actividades de la corporación en el año 2025”, se anotó.
Se añadió que el Ministerio de Agricultura dio a conocer el proyecto de resolución que ordena la transferencia de recursos de esa cartera a Agrosavia para su operación y que esta se encuentra en consulta pública en el portal Sucop.gov.co para observaciones de la comunidad.
“Como se ha realizado en el pasado, una vez esté firmada la resolución se activará el pago de los salarios pendientes”, indicó Agrosavia, aunque sin precisar el monto de esas obligaciones.
Voceros de Agrosavia mencionaron que conoce de la realización de marchas previstas para este martes, 18 de febrero, organizadas por los trabajadores en todo el país. “Respetamos el derecho a manifestarse de manera pacífica privilegiando el respeto a las instituciones que nos ha caracterizado siempre como equipo”, se agregó.
La entidad es ejemplo en el Programa de Formalización del Empleo Público promovido por el actual gobierno; a cierre de diciembre 2024 se contaba con una planta de 2.020 personas de las cuales el 90% estaba vinculada mediante contrato a término indefinido. “Dada la magnitud del recorte es necesario reducir el tamaño de la planta de personal garantizando que se paguen las indemnizaciones previstas en la Ley por la terminación sin justa causa”, precisó Agrosavia.
En ese contexto, tan pronto se informó a la institución del recorte se empezaron a tomar las medidas necesarias para enfrentar la crisis. La totalidad del equipo de Agrosavia se dedicó a identificar los gastos que pudieran ser principalmente aplazados y otros eliminados con el fin de superar este momento tan desafiante que pone en riesgo la viabilidad de la corporación. Como resultado de este ejercicio a la fecha se han tomado medidas a través de las cuales se recortan los gastos de operación en $44.000 millones.
“Dichas medidas serán presentadas a la junta directiva de Agrosavia en los próximos días para continuar analizando esta situación y obtener su orientación y la eventual aprobación de medidas adicionales, buscando que el impacto en la reducción del equipo humano sea el menor posible. Conscientes de la necesidad de diversificar las fuentes de financiamiento de Agrosavia, continuaremos gestionando recursos diferentes a la transferencia del Presupuesto General de la Nación para responder a las necesidades de los productores del campo. Como resultado de esta gestión exitosa, la corporación ha movilizado en el último trienio recursos superiores a los $196.000 millones”, se explicó.
Por supuesto, para mantener los logros será necesario que Agrosavia cuente con el equipo científico, aunque se admitió que se suspendieron 22 procesos de selección y contratación que se encontraban en desarrollo.

Regístrate al newsletter
Regístrate al newsletter